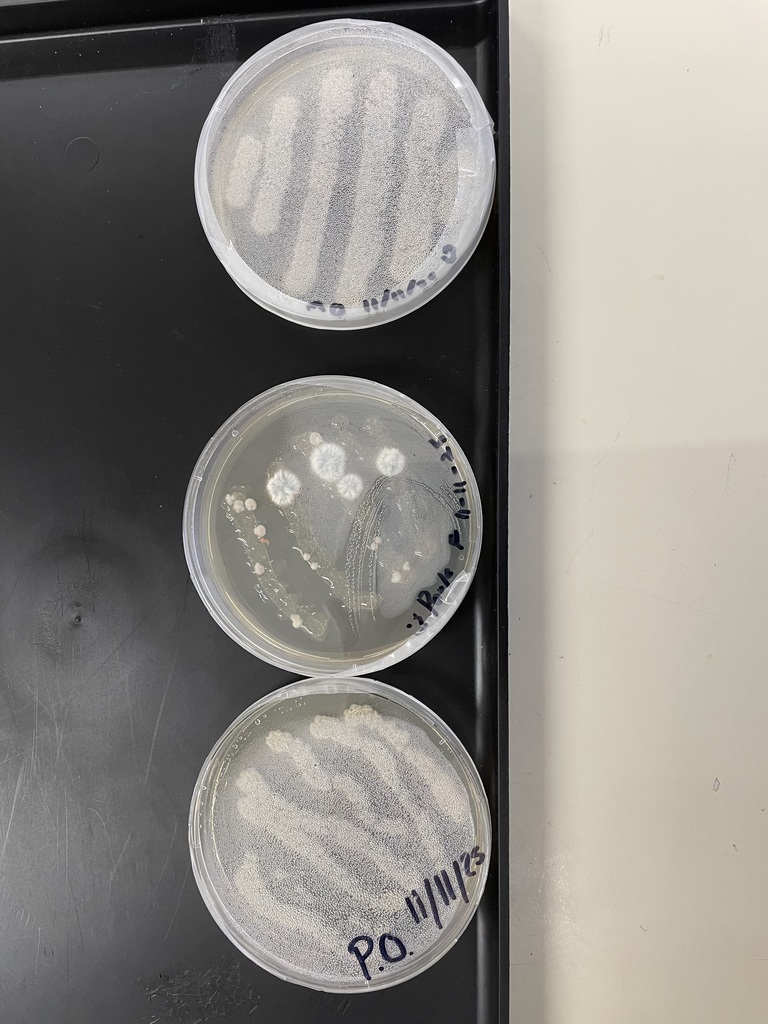
fs4

THIS WEEK!
Viking Wrestling is having a mini dual match right here in Petersburg City!
Check out the details below! Come see your vikings wrestle!

The Boys Viking Basketball team is having a Kalua Pork Dinner fundraiser and alumni event, Saturday, December 13th. Yes, it is the night of the recital. Order your dinners and make a hectic night easy on yourself. Dine in or carry out, tickets on sale now, $25 a dinner.
Looking for some basketball action before the recital? Boys scrimmages start at 1 pm, and the Alumni vs. Boys Varsity game is at approximately 4:00 pm. It will be the only time to see the Varsity Boys play at home until January 23rd. Come out and cheer them on! If you would like dinner tickets, let us know to send a player your way.

Mark your calendars!!
The MMS Winter Concert is happening in just a couple of weeks! See you there!

Mark your calendars!!
The PHS Winter Concert is happening in just a couple of weeks! See you there!

Petersburg School Community November Newsletter
Happy Thanksgiving
HS Physics!
In Mrs. Ward’s Physics class, students are exploring momentum, collisions, and the forces that occur during sudden changes in motion. They put these concepts into action by designing cars that keep eggs as “passengers” safe. Their challenge: design, build, test, and improve a protective device that keeps the egg intact upon impact. Through hands-on experimentation, students are discovering the real-world physics behind airbags, crumple zones, and seat belts, while learning how mass, velocity, and momentum determine the outcome of collisions. This engaging lab helps students see how physics explains everyday motion and keeps people safe in the real world.





HS Food Science Class!
In Mrs. Ward's Food Science class, students are diving into food safety with a hands-on lab focused on bacterial growth. They’re cultivating bacteria from meat and spinach samples stored under different conditions: some left at room temperature on the counter for 24 hours, and others kept in the refrigerator. After incubation, students are observing and comparing bacterial colonies on Petri dishes filled with nutrient-rich agar. Through this experiment, they gain insights into how storage conditions impact bacterial growth and learn valuable lessons on safe food handling practices.

Check out PHS Chemistry!
In Mrs. Ward’s Intro to Chemistry class, students are uncovering the roots of chemistry through early human practices. Last week, they explored the intriguing process of lactic acid fermentation—a preservation method used by ancient civilizations to keep vegetables safe and flavorful. Through hands-on activities, students are discovering how chemistry has shaped daily life for thousands of years and how lactic acid bacteria naturally transform fresh vegetables into delicious, tangy pickles.





Thursday Petersburg vs. Haines 4:15 p.m.

HIGH SCHOOL CHEER!
Informational meeting tomorrow, Wednesday 11/12, in the Cantina @ 3:15pm!


Congratulations to the PHS Girls Swim Team - they represented Petersburg well by being awarded the 2025 ASAA State Championships Sportsmanship Team Award!




Congrats and good luck to our amazing swimmers!!!
Go Vikings!

Please read the donor match announcement!!

Happy Halloween PHS Volleyball!!
Here is the planned link for streaming Volleyball games from Ketchikan this weekend! So tune in!
https://k21schools.eduvision.tv/default
See the schedule below!

PHS Honors Concert TONIGHT Live Streaming from Wrangell!
7:00 PM! Click on the link:
https://www.youtube.com/@WPSD_Streaming

UPDATED SCHEDULE!
Be sure to check this updated schedule for the Valkyrie Volleyball tournament this weekend!

Lady Viking Volleyball Tournament schedule this weekend!
Check it out! Come cheer our valkyries on!

